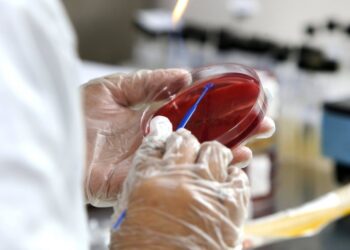
Infectologistas projetam predomínio da delta entre outubro e novembro em Salvador

Salvador: Mulher é internada após ser picada por aranha
4 de janeiro de 2022
Colégio da Polícia Militar da Bahia abre inscrições nesta segunda-feira
3 de maio de 2021
Lesão grave! Bahia divulga diagnóstico e goleiro passará por cirurgia
28 de maio de 2026
Candeias Run: 3ª edição da corrida arrecada mais de 1 tonelada de alimentos
28 de maio de 2026